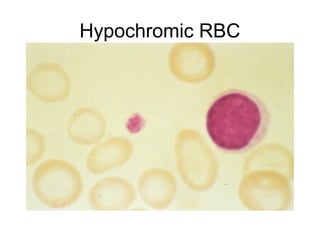
Hypochromic RBC
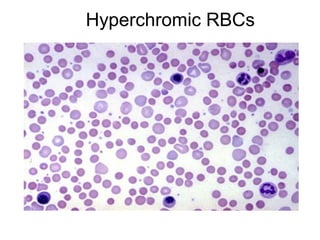
Hyperchromic RBCs
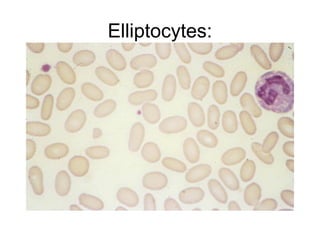
Elliptocytes:
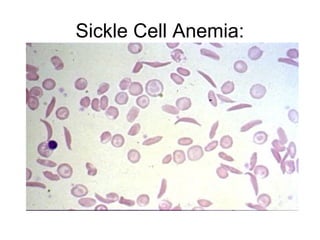
Sickle Cell Anemia:
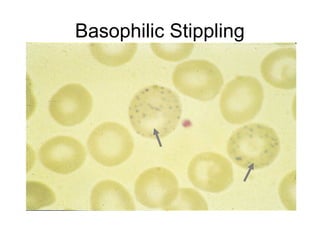
Basophilic Stippling
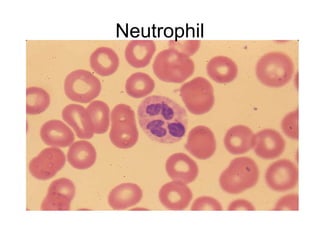
Neutrophil
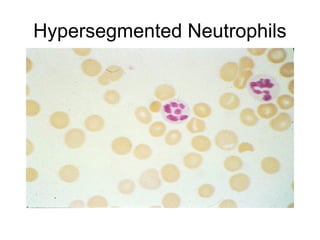
Hypersegmented Neutrophils
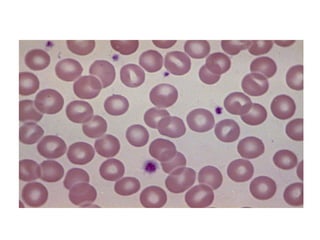
Peripheral smear

This document provides information about performing and interpreting a peripheral blood smear. It discusses examining red blood cells for morphology, abnormalities in shape and distribution, and inclusions. White blood cell morphology of neutrophils, eosinophils, basophils, monocytes, and lymphocytes is also described. Platelet morphology and abnormalities in platelet count are briefly covered. The preparation, staining, and examination process for a peripheral blood smear is outlined.

![Abnormalities of Shape
6.Acantocytes
• RBCS with fewer thorn like projection of
varying sizes and variable in number
• more blunted than Echinocytes.
Seen in
• Disorders of liquid metabolism
• chronic liver disease ] Acquired.
• Spur cell anemia](https://image.slidesharecdn.com/peripheralsmearnew-140817074554-phpapp01/85/Peripheral-smear-29-320.jpg)